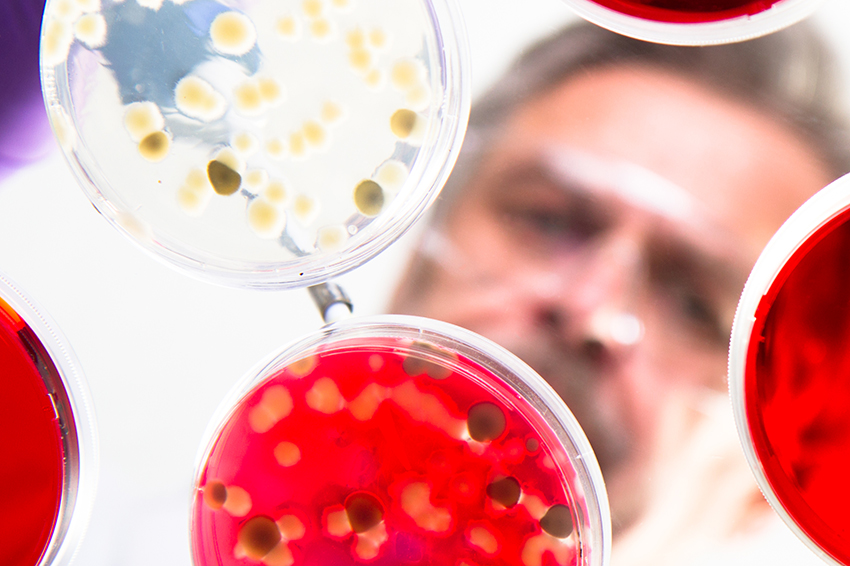

Около 150 ученых, юристов и представителей бизнеса стали участниками прошедшего в медицинской школе Гарварда совещания о создании синтетического человеческого генома, который помимо расширения возможностей генной инженерии откроет прямой путь к созданию искусственного человека.
По информации обозревателя The New York Times Эндрю Поллака (Andrew Pollack), мероприятие проходило в закрытом режиме, а присутствовавших настойчиво попросили не распространяться о событии в прессе или социальных сетях.
Создание синтетического генома серьезно отличается от уже применяемого редактирования - речь идет не о модификации какого-либо гена, а о получении всех компонентов ДНК с помощью химических соединений. Искусственные базовые пары позволят биологам преодолеть природные ограничения в экспериментах с организмами. В перспективе технология станет отправной точкой для создания так называемого "квази-человека" - не имеющего родительских связей на генетическом уровне, то есть находящегося вне биологического вида.
После того, как сведения о закрытой встрече просочились в СМИ, ее организатор - профессор генетики Гарварда Джордж Черч (George Church) заявил, что участники обсуждали не синтетический геном человека, а пути улучшения синтезирования длинных нитей ДНК, которые можно было бы применять для создания различных животных, растений и микроорганизмов. Тайный характер совещания он объяснил планами публикации результатов работы в научном журнале.
Вместе с тем Поллак обращает внимание, что проект Черча изначально назывался "HGP2: The Human Genome Synthesis Project" - "HGP2: Проект синтетического генома человека", а в приглашениях указывалось, что ключевой задачей технологии является "синтезирование полноценного генома человека в клеточной линии в течение ближайших 10 лет". Позже название было изменено на "HGP-Write: Testing Large Synthetic Genomes in Cells" - "Проект "Геном человека": Исследование крупных синтетических геномов в клетках".
Журналист также отметил, что ряд видных американских научных деятелей были приглашены, но отказались от участия в совещании именно из-за его закрытости. По их мнению, завеса тайны не дает представителям общественности возможности обсудить этические последствия работы генетиков.
Кроме того, они ставят под сомнение вероятность создания искусственного генома за период в 10 лет. Нечто подобного в 2010 году достигла группа исследователей под руководством генетика Крейга Вентера, получившая бактерию с ДНК из искусственного генома, состоящего из примерно одного миллиона нуклеотидов. В человеческом геноме содержится более трех миллиардов нуклеотидов.
Подписывайтесь на основные новости "РГ" в Telegram telegram.me/rgrunews